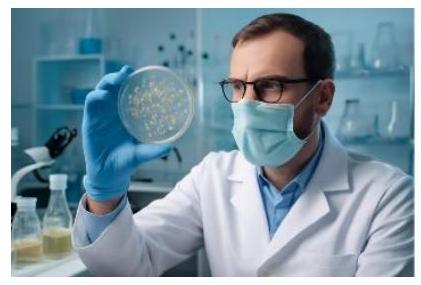

Giả sử số lượng của một quần thể nấm men tại môi trường nuôi cấy trong phòng thí nghiệm
Giả sử số lượng của một quần thể nấm men tại môi trường nuôi cấy trong phòng thí nghiệm được mô hình hóa bằng hàm số $P(t) = \dfrac{a}{b + e^{- 0,75t}}$; trong đó: $a,b$ là các số thực và thời gian $t$ được tính bằng giờ. Tại thời điểm ban đầu $t = 0$, quần thể có 20 tế bào và không ngừng tăng lên với tốc độ 12 tế bào/giờ. Số lượng của quần thể nấm này tại thời điểm $t = 8$ giờ là bao nhiêu tế bào (làm tròn đến hàng đơn vị)?
Đáp án đúng là:
Quảng cáo
Tính $P'(t)$. Từ điều kiện $P\left( {0 = 20} \right);P'(0) = 12$ tìm a, b. Từ đó tính $P(8)$
Đáp án cần điền là: 99
>> 2K8 Chú ý! Lộ Trình Sun 2026 - 3IN1 - 1 lộ trình ôn 3 kì thi (Luyện thi 26+ TN THPT, 90+ ĐGNL HN, 900+ ĐGNL HCM, 70+ ĐGTD - Click xem ngay) tại Tuyensinh247.com.Đầy đủ theo 3 đầu sách, Thầy Cô giáo giỏi, luyện thi theo 3 giai đoạn: Nền tảng lớp 12, Luyện thi chuyên sâu, Luyện đề đủ dạng đáp ứng mọi kì thi.
![]() |
![]() |
![]() |
![]() |
![]() |
![]() |
![]() |
![]() |
Hỗ trợ - Hướng dẫn
-
024.7300.7989
-
1800.6947
(Thời gian hỗ trợ từ 7h đến 22h)
Email: lienhe@tuyensinh247.com












